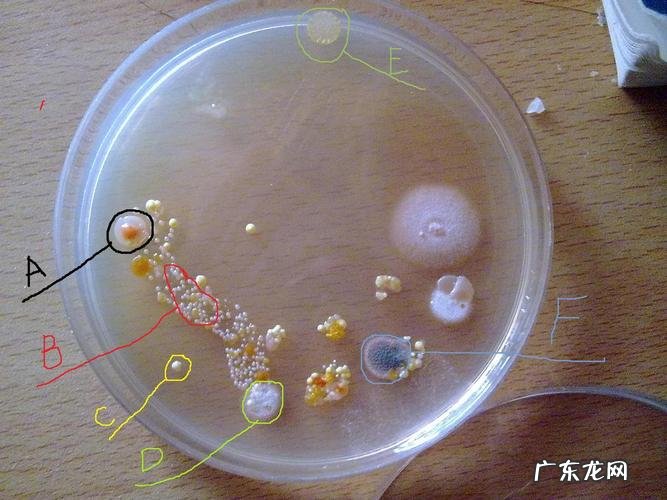

文章插图
【如何全自动计数培养皿上的微生物、菌落】同时6平皿的大通量自动计数分析,省力省心,对于疾控等大量应急计数情形,尤其要考虑采用 。因此,可选择集成上述各优点的自动计数分析系统 。通常,这种仪器具有暗视野成像、背光亮度可调、分辩率可调(600dpi成像就相当于2960万像素以上的拍照效果)等特性,并为多用途的仪器 。
- 小猫应该吃什么食物?如何正确喂养它们?
- 纯银市场价格多少钱一克?教你如何辨别纯银和假白银!
- 黄金回收价多少?黄金价格走势如何?
- 如何制作电子公章
- 三九天养生 三九天如何养生
- 如何防止培养皿上的水蒸气
- 沉香的现在价格是多少?如何辨别真假沉香?
- 如何让iPhone变得更加流畅
- 如何让你的猫变得更胖?
- 如何帮助猫咪学会使用猫砂盆?
特别声明:本站内容均来自网友提供或互联网,仅供参考,请勿用于商业和其他非法用途。如果侵犯了您的权益请与我们联系,我们将在24小时内删除。
